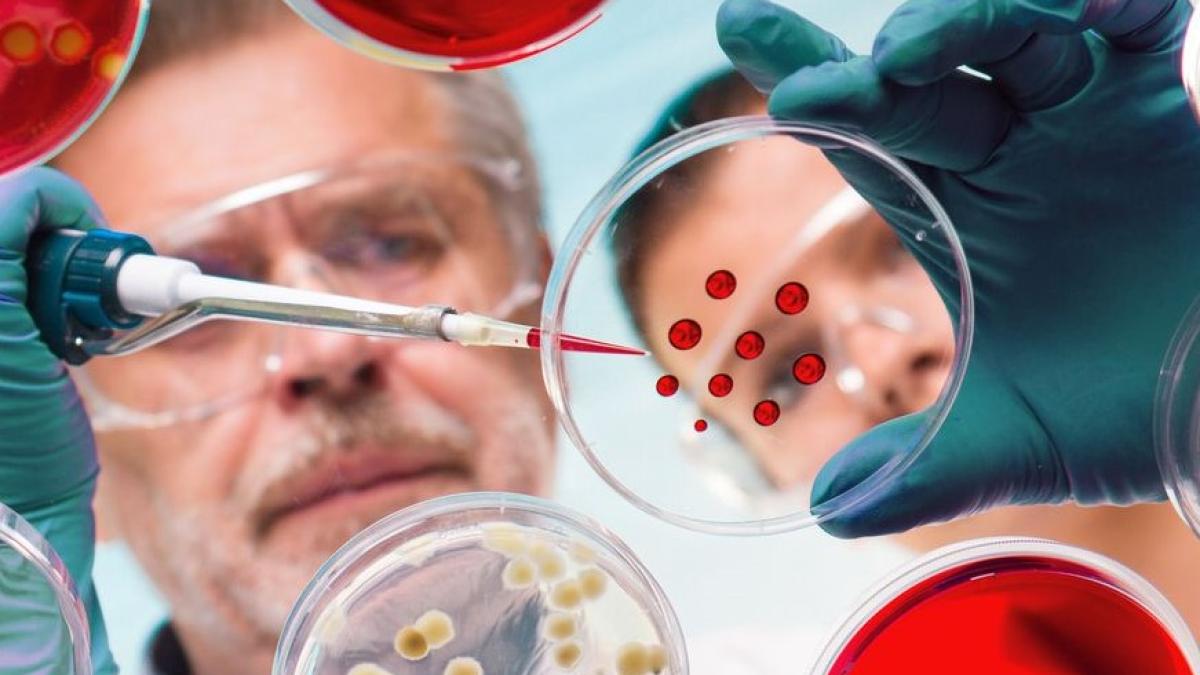
bacterii_54795400

Potrivit estimărilor oamenilor de știință americani, la fiecare 11 secunde un om este infectat de o astfel de bacterie care nu poate fi combătută cu nici unul dintre tratamentele aplicate în prezent pentru astfel de cazuri. Iar situația este cu atât mai gravă cu cât în ultimele trei decenii nu a fost creată nici o nouă clasă de antibiotice. Cu toate acestea, mortalitatea a scăzut cu 30% grație metodelor perfecționate de ținere sub control a agenților patogeni în spitale, acolo unde apar cel mai des infecțiile.
Citește și Epidemiile de gripă în istorie. Mai devastatoare decât războaiele
Cei mai periculoși microbi sunt Clostridioides difficile (generează infecții mortale pe fondul deteriorării microflorei intestinale din cauza antibioticelor), rezistenți la toate sau aproape toate medicamentele tradiționale. Pentru a reduce riscul de infecție, specialiștii recomandată respectarea normelor de igienă a mâinilor, vaccinarea, prepararea corectă a produselor alimentare.